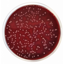

2xYT médium
Pro kultivaci rekombinantních kmenů E. coli a pro růst vláknitých bakteriofágů. Tento produkt je dodáván v dehydratované formě a je určen pro přípravu hotových kultivačních médií.
Kultivační půda používaná pro izolaci a kultivaci termofilních patogenních bakterií rodu Campylobacter, náročných mikroorganismů a stanovení hemolytických reakcí. Tento produkt je dodáván v dehydratované formě a je určen pro přípravu hotových kultivačních médií.

| Kat. číslo | Balenie | Rozmery | Regulačný status produktu | Cena bez DPH | |||
|---|---|---|---|---|---|---|---|

|
Columbia agar (základ) | Kat. číslo LC1104 | Balenie 500 g | Rozmery | Regulačný status produktu CE IVD | ||
|
Columbia agar (základ) | Kat. číslo LC1104-5kg | Balenie 5 kg | Rozmery | Regulačný status produktu CE IVD |
Columbia agar (základ) (Columbia Agar Base) je vysoce výživné univerzální médium pro kultivaci náročných mikroorganismů, zejména pokud se používá jako základ pro čokoládový agar. Lze jej také použít jako selektivní izolační médium přidáním antimikrobiálních látek. Je vhodné pro izolaci a kultivaci široké škály mikroorganismů s obtížnými růstovými vlastnostmi. Přidáním krve jej lze použít ke stanovení hemolytických reakcí. Většina běžných patogenních bakterií však dobře roste i bez přídavku krve.
Pankreatický digestát kaseinu, peptický digestát masa a pankreatický digestát srdce poskytují dusík, vitamíny, minerály a aminokyseliny nezbytné pro růst. Kvasnicový extrakt a kukuřičný škrob jsou zdrojem vitamínů, zejména vitamínů skupiny B, které jsou nezbytné pro bakteriální růst. Chlorid sodný dodává esenciální elektrolyty pro transport a osmotickou rovnováhu. Bakteriologický agar slouží jako ztužující látka. Krev je dalším zdrojem růstových faktorů pro mikroorganismy a je základem pro stanovení hemolytických reakcí. Hemolytické vzory se mohou lišit podle typu použité krve nebo základního média. Například defibrinovaná ovčí krev poskytuje nejlepší výsledky pro streptokoky skupiny A.
Pro zvýšení selektivity média lze v případě potřeby přidat následující doplňky:
Evropský lékopis USP doporučuje v odstavci 2.6.13 "Mikrobiologické vyšetření nesterilních výrobků: zkouška na přítomnost specifikovaných mikroorganismů" pro testování klostridií ve výrobcích Columbia Agar Base.
Norma ISO 10272 uvádí, že Columbia Agar Base s krví lze použít k umožnění vývoje dobře izolovaných kolonií, aby bylo možné tyto kolonie použít v konfirmačních testech.
Po přidání 5-10 % sterilní defibrinované krve a zejména s doplňkem Polyenrichment Supplement (LC6011) a VCN Supplement (LC6013) se Columbia Agar Base stává vynikajícím čokoládovým agarem, který lze použít k izolaci patogenních neisserií, gonokoků a meningokoků stejně dobře nebo lépe než Thayer-Martinovo médium. V závislosti na výběru inhibitorů mohou být alternativními doplňky k VCNT (LC6026) nebo VCAT (LC6014).